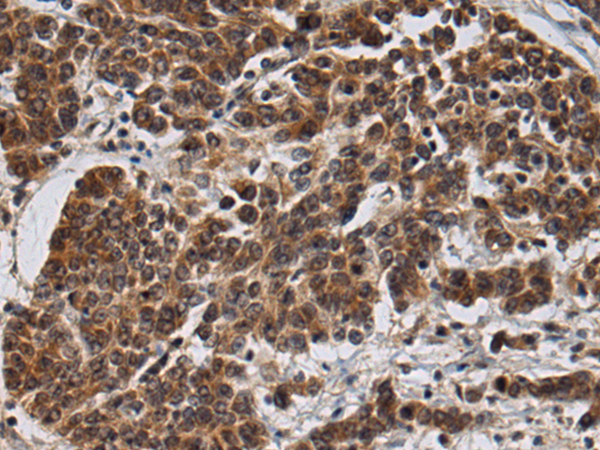
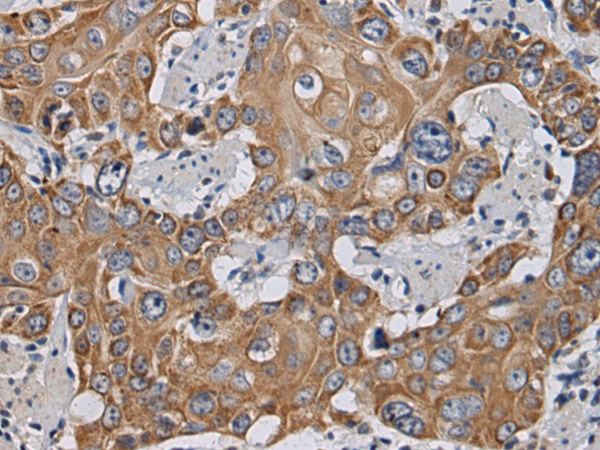
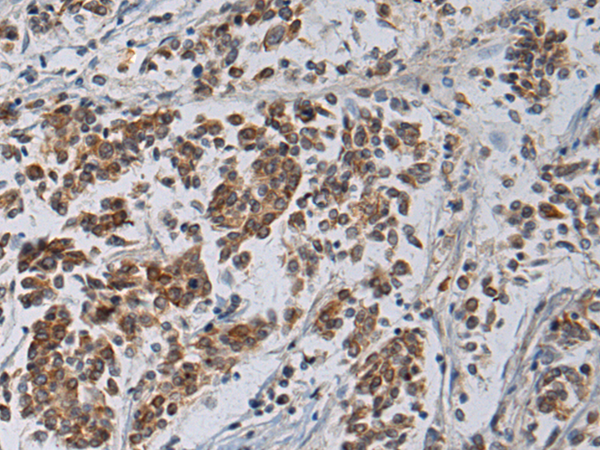
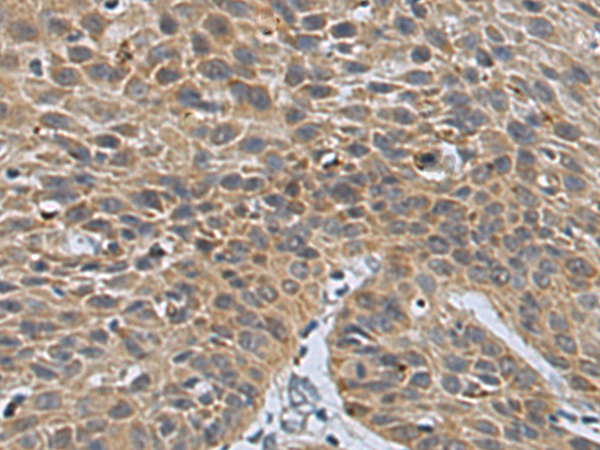
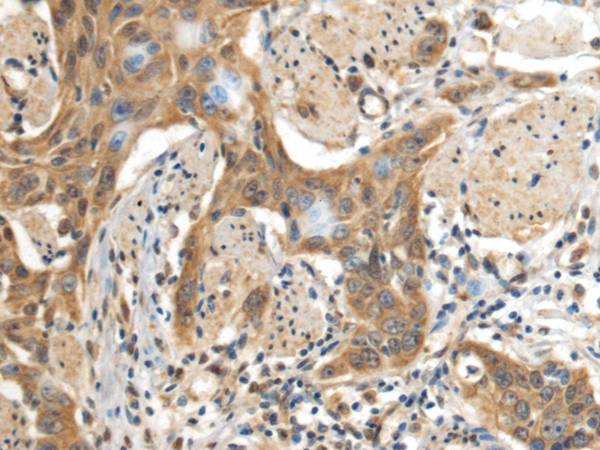
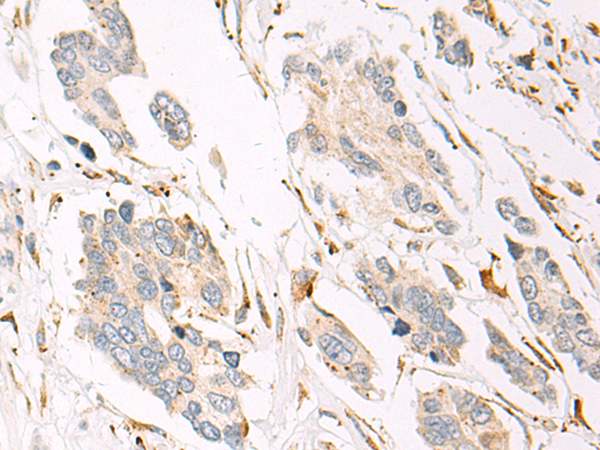

-
分类: 科研抗体货号: P10512别名: DIP2; C21orf106应用: IHC反应种属: Human, Mouse
-
分类: 科研抗体货号: P10528别名: AD-017; MSTP139应用: WB,IHC反应种属: Human, Mouse, Rat
-
分类: 科研抗体货号: P10545别名: AMRF; EPM4; LGP85; CD36L2; HLGP85; LIMP-2; LIMPII; SR-BII应用: IHC反应种属: Human, Mouse, Rat
-
分类: 科研抗体货号: P10527别名: TSK4; TSK-4; TSSK5; STK22E; C14orf20应用: IHC反应种属: Human, Mouse
-
分类: 科研抗体货号: P10561别名: IPOA7应用: IHC反应种属: Human, Mouse
-
分类: 科研抗体货号: P10543别名: E46L; SCA10; HUMEEP应用: WB,IHC反应种属: Human
-
分类: 科研抗体货号: P10526别名:应用: WB,IHC反应种属: Human
-
分类: 科研抗体货号: P10560别名: MYP25应用: IHC反应种属: Human, Mouse
-
分类: 科研抗体货号: P10542别名: FMO1B1应用: WB反应种属: Human, Mouse, Rat
-
分类: 科研抗体货号: P10525别名: GSDM; FKSG9; GSDM1应用: WB,IHC反应种属: Human, Mouse

鄂公网安备42018502007531号
鄂公网安备42018502007531号

